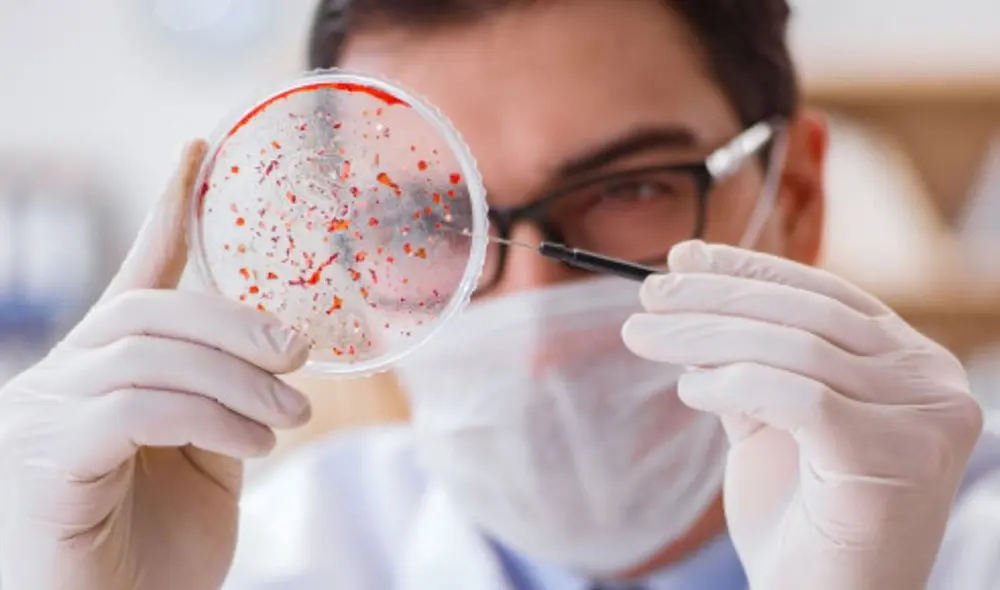
La OMS señala que es urgente realizar más estudios sobre las mutaciones de la variante Lambda. Foto referencial: Freepik

Por qué una variante identificada en Perú es ahora de interés mundial
Lambda, también llamada C.37, ha entrado en la lista de variantes potencialmente peligrosas de la OMS. ¿Qué está pasando con esta versión del coronavirus?
- La NASA descubre moléculas de ARN en el asteroide Bennu que explicarían el origen de la vida
- Los astrónomos se sorprenden: detectan en la superficie del cometa 3I/ATLAS unas erupciones ‘volcánicas’ pero de hielo
Una variante del coronavirus detectada por primera vez en Perú y presente en al menos 29 países ha sido declarada “de interés” por la Organización Mundial de la Salud (OMS).
Se trata la variante C.37, que en los últimos meses se expandió principalmente en Perú y Chile, razón por la que también se hizo conocida como “variante andina”. Sin embargo, la OMS la ha designado oficialmente como “Lambda”, conforme a su reciente decisión de usar letras griegas para nombrar a los linajes más importantes del virus.
Actualmente circulan miles de variantes del SARS-CoV-2 en todo el mundo, pero solo unas pocas son vigiladas por la OMS. Estas son divididas en dos categorías: “de interés” y “de preocupación”.
Las variantes de interés, que hasta ahora son siete, tienen indicios de ser más contagiosas o resistentes a los anticuerpos. En tanto, las variantes de preocupación han demostrado tener estas características. En esta categoría están Alfa (”británica”), Beta (”sudafricana”), Gamma (”brasileña”) y Delta (”india”).
Cada vez más casos
En el caso de Lambda, la OMS indica que “se ha asociado con tasas sustanciales de transmisión comunitaria en varios países”, donde ha tenido una presencia cada vez mayor.
Lambda fue identificada por primera vez en Perú en agosto de 2020, pero su propagación se hizo notoria en abril de 2021. Desde entonces, el 81% de los casos de COVID-19 secuenciados en el país corresponden a esta variante.

A man carries an empty oxygen tank as he arrives to queue to refill it in Villa El Salvador, on the southern outskirts of Lima, on April 11, 2021, amid the COVID-19 coronavirus pandemic. - Relatives of COVID-19 patients are desperate for oxygen to keep their loved ones alive during a fierce second wave of the pandemic in Peru, during the day of the first round of presidential and parliamentary elections. (Photo by ERNESTO BENAVIDES / AFP)
En Argentina y Chile, la prevalencia de Lambda ha aumentado con el tiempo y se ha detectado en más de la tercera parte de los casos secuenciados en los últimos meses. Asimismo, Ecuador ha reportado una amplia expansión de este linaje del SARS-CoV-2.
Mutaciones sospechosas
El aumento de prevalencia de Lambda puede deberse a sus propias características. En ese sentido, la OMS indica que esta variante porta una serie de mutaciones que podrían darle un “aumento de la transmisibilidad” o un “aumento de la resistencia a los anticuerpos neutralizantes” generados por la infección previa o la vacunación.
Las mutaciones son cambios genéticos que modifican la estructura del virus y, en ocasiones, pueden alterar su comportamiento.
La OMS resalta que Lambda posee nueve mutaciones en la proteína espícula, usada por el virus para entrar en la célula e infectarla.

Modelo tridimensional del SARS-CoV-2, el virus de la COVID-19. Imagen: Visual Science
Algunas de esas mutaciones fueron detalladas en un anterior artículo.
Sin embargo, los expertos advierten que hasta ahora hay escasa evidencia sobre el impacto de estos cambios genéticos. Por tanto, la OMS señala que es urgente realizar más estudios sobre la variante Lambda, sobre todo para comprender “mejor el impacto de las contramedidas y controlar la propagación”.
Asimismo, las futuras investigaciones deben determinar si las vacunas siguen siendo efectivas frente a esta variante.


















